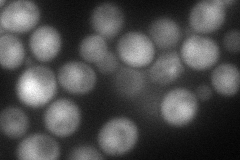
YIL139C
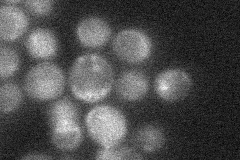
YIL139C

View description
Accessory subunit of DNA polymerase zeta, involved in translesion synthesis during post-replication repair; required for mutagenesis induced by DNA damage; involved in double-strand break repair
Localization:
Intensity:
Fold change:
Significance:
-
C’ GFP library in SD

below threshold18.11 -
N' NOP1pr-GFP in SD

cytosol,nucleus55.0647 -
N' TEF2pr-mCherry in SD
nucleus94.3451 -
N' NATIVEpr-GFP in SD
below threshold19.9525 -
N' TEF2pr-VC and Cyto-VN in SD

#N/A0 -
C’ GFP library in SD+DTT

cytosol18.341.01No -
C’ GFP library in SD+H2O2

cytosol14.910.82No -
C’ GFP library in Starvation Media

cytosol17.440.96No -
C’ GFP library on the background of Pup2-DaMP

below threshold -
C’ GFP library on the background of CCT mutant

below threshold17.60830.971995No
